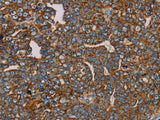
MRPL28 Polyclonal Antibody Store at -20°C

MRPL28 Polyclonal Antibody Store at -20°C
SKU: E-AB-11405-200
MRPL28 Polyclonal Antibody Store at -20°C
| SKU # | E-AB-11405 |
| Reactivity | Human, Mouse |
| Host | Rabbit |
| Applications | WB, IHC |
Product Details
| Isotype | IgG |
| Host | Rabbit |
| Reactivity | Human, Mouse |
| Applications | WB, IHC |
| Clonality | Polyclonal |
| Immunogen | Recombinant protein of human MRPL28 |
| Abbre | MRPL28 |
| Synonyms | 39S ribosomal protein L28, 39S ribosomal protein L28 mitochondrial, 39S ribosomal protein L28 mitochondrial precursor, HGNC6756, L28mt, MAAT 1, MAAT1, Melanoma antigen p15, Melanoma associated anti, Melanoma associated antigen recognised by cytotoxic T lymphocytes |
| Swissprot | |
| Calculated MW | 30 kDa |
| Cellular Localization | Mitochondrion. |
| Concentration | 0.6 mg/mL |
| Buffer | Phosphate buffered solution, pH 7.4, containing 0.05% stabilizer and 50% glycerol. |
| Purification Method | Affinity purification |
| Research Areas | Cancer, Epigenetics and Nuclear Signaling |
| Conjugation | Unconjugated |
| Storage | Store at -20°C Valid for 12 months. Avoid freeze / thaw cycles. |
| Shipping | The product is shipped with ice pack,upon receipt,store it immediately at the temperature recommended. |
Related Reagents
| Applications | Recommended Dilution |
| WB | 1:1000-1:5000 |
| IHC | 1:100-1:300 |
Background
Mammalian mitochondrial ribosomal proteins are encoded by nuclear genes and help in protein synthesis within the mitochondrion.Mitochondrial ribosomes (mitoribosomes) consist of a small 28S subunit and a large 39S subunit.They have an estimated 75% protein to rRNA composition compared to prokaryotic ribosomes, where this ratio is reversed.Another difference between mammalian mitoribosomes and prokaryotic ribosomes is that the latter contain a 5S rRNA.Among different species, the proteins comprising the mitoribosome differ greatly in sequence, and sometimes in biochemical properties, which prevents easy recognition by sequence homology.